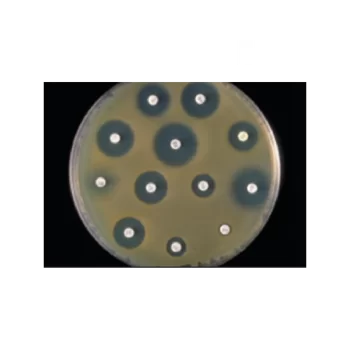
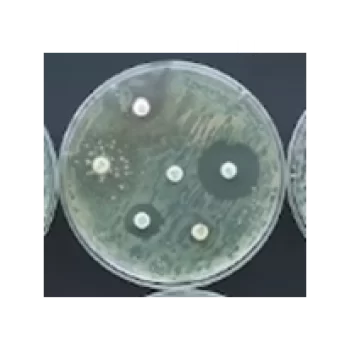

Showing 64–72 of 194 results
Haemophilus Test Medium Base (Dehydrated) / Base de medio de prueba de Haemophilus (deshidratado)
S/ 0.00
[SKU: CM0898B]
Lleve a cabo pruebas de susceptibilidad de Haemophilus influenzae con la base del medio de prueba Thermo Scientific™ Oxoid™ Haemophilus (deshidratado).
Kligler Iron Agar (Dehydrated) / Agar hierro Kligler (deshidratado)
S/ 0.00
[SKU: CM0033B]
Identifique enterobacterias basándose en la fermentación doble de azúcar y la producción de sulfuro de hidrógeno utilizando el agar hierro Kligler Thermo Scientific™ Oxoid™ (deshidratado).
Lactose Broth (Dehydrated) / Caldo Lactosa (Deshidratado)
S/ 0.00
[SKU: CM0137B]
Identifique presuntamente organismos coliformes en la leche, el agua y los alimentos según lo especificado por la Asociación Estadounidense de Salud Pública 1,2,3 con el caldo de lactosa Thermo Scientific™ Oxoid™ (deshidratado).
Lauryl Tryptose Broth (Dehydrated) / Caldo de lauril triptosa
S/ 0.00
[SKU: CM0451B]
Detecte organismos coliformes en agua, aguas residuales y productos lácteos con el caldo de lauril triptosa selectivo Thermo Scientific™ Oxoid™ (deshidratado), cumpliendo con la fórmula detallada por la Asociación Estadounidense de Salud Pública.
Lincomycin Discs for Oxoid™ Antibiogram / Discos de lincomicina para antibiograma Oxoid™
S/ 0.00
[SKU: CT0027B]
Evalúe la sensibilidad de los microorganismos utilizando métodos AST manuales, con la ayuda de una amplia selección de discos para antibiogramas.
Lincomycin Discs for Oxoid™ Antibiogram / Discos de lincomicina para antibiograma Oxoid™
S/ 0.00
[SKU: CT0028B]
Evalúe la sensibilidad de los microorganismos utilizando métodos AST manuales, con la ayuda de una amplia selección de discos para antibiogramas.
Lincomycin Discs for Oxoid™ Antibiogram / Discos de lincomicina para antibiograma Oxoid™
S/ 0.00
[SKU: CT0123B]
Evalúe la sensibilidad de los microorganismos utilizando métodos AST manuales, con la ayuda de una amplia selección de discos para antibiogramas.
Lysine Decarboxylase Broth Tablets (Taylor Modification) (Dehydrated) / Tabletas de caldo de lisina descarboxilasa (modificación de Taylor) (deshidratadas)
S/ 0.00
[SKU: CM0308S]
Detecte la producción de lisina descarboxilasa por salmonelas y otras enterobacterias con las tabletas de caldo de lisina descarboxilasa Thermo Scientific™ Oxoid™ (modificación de Taylor) (deshidratadas).
MacConkey Agar No. 3 (Dehydrated) / Agar MacConkey N° 3 (deshidratado)
S/ 0.00
[SKU: CM0115B]
Detecta y enumera organismos coliformes, incluida Escherichia coli , mientras aísla y detecta Salmonella y Shigella spp. en muestras clínicas y alimentarias utilizando el agar Thermo Scientific™ Oxoid™ MacConkey n.º 3.